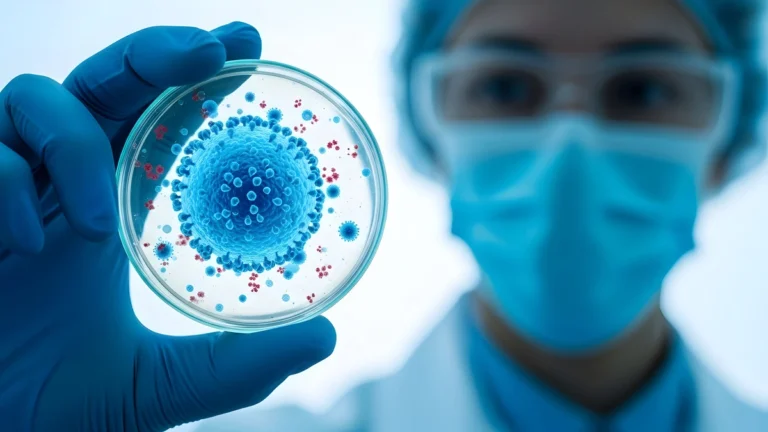
Virus Nipah : pourquoi cette apparition inquiète les autorités sanitaires virus scientifique

L’alerte sanitaire a été déclenchée dans l’État du Bengale-Occidental où un virus rare mais potentiellement mortel vient de faire son apparition. Les autorités indiennes ont confirmé plusieurs cas d’infection au virus Nipah, un agent pathogène considéré comme hautement dangereux par l’Organisation mondiale de la Santé, poussant les pays voisins à renforcer leur vigilance.
Une situation préoccupante dans le Bengale-Occidental
Les autorités sanitaires indiennes ont confirmé cinq cas de contamination au virus Nipah dans l’État du Bengale-Occidental. Cette découverte a immédiatement déclenché des mesures de précaution importantes, notamment la mise en quarantaine d’une centaine de personnes ayant été potentiellement exposées au virus.
Le virus Nipah n’est pas un inconnu dans cette région du monde. Il a été identifié pour la première fois en Inde et au Bangladesh en 2001, mais cette nouvelle vague d’infections ravive les inquiétudes des autorités sanitaires.
Un virus à la létalité inquiétante
Ce qui préoccupe particulièrement les experts, c’est le taux de mortalité exceptionnellement élevé de ce virus, oscillant entre 40% et 75% selon les épidémies. À ce jour, aucun vaccin ni traitement spécifique n’existe pour combattre cette maladie.
« Ce virus peut occasionner de très sévères infections chez les humains », confirme Marie-Anne Rameix-Welti de l’Institut Pasteur, soulignant la gravité potentielle des cas.
Symptômes et évolution de la maladie
Les personnes infectées présentent initialement des symptômes qui peuvent sembler banals :
- Fièvre
- Migraines intenses
- Douleurs musculaires
Mais l’évolution peut rapidement se compliquer vers des problèmes neurologiques et respiratoires graves, pouvant entraîner le décès du patient.
Origine et transmission du virus
Le Nipah est un virus zoonotique, principalement transmis par les chauves-souris géantes frugivores du genre Pteropus, également connues sous le nom de « renards volants ». Les porcs peuvent également servir d’hôtes intermédiaires dans la chaîne de transmission.
La contamination interhumaine reste heureusement limitée et nécessite des contacts rapprochés avec une personne infectée, ce qui explique pourquoi les épidémies prennent généralement la forme de petits clusters familiaux ou communautaires.
Mesures de surveillance internationales
Cette récente apparition du virus a conduit la Thaïlande à renforcer sa surveillance aux postes-frontières. Jusqu’à présent, aucun cas n’a été signalé en Europe, mais les autorités sanitaires restent vigilantes.
Perspectives et évaluation du risque
Des investigations sont actuellement en cours pour comprendre l’origine précise de cette nouvelle émergence et limiter sa propagation. Les experts soulignent que malgré la dangerosité du virus, la situation n’est pas considérée comme une alerte pandémique.
La transmission inefficace entre humains et l’apparition généralement localisée du virus en petits clusters constituent des facteurs rassurants quant à son potentiel de diffusion mondiale.
Néanmoins, les autorités sanitaires restent mobilisées face à cette menace qui rappelle l’importance de la surveillance des maladies émergentes et de la coopération internationale en matière de santé publique.

Un commentaire
« petits clusters »
En français, on dit « foyers ».